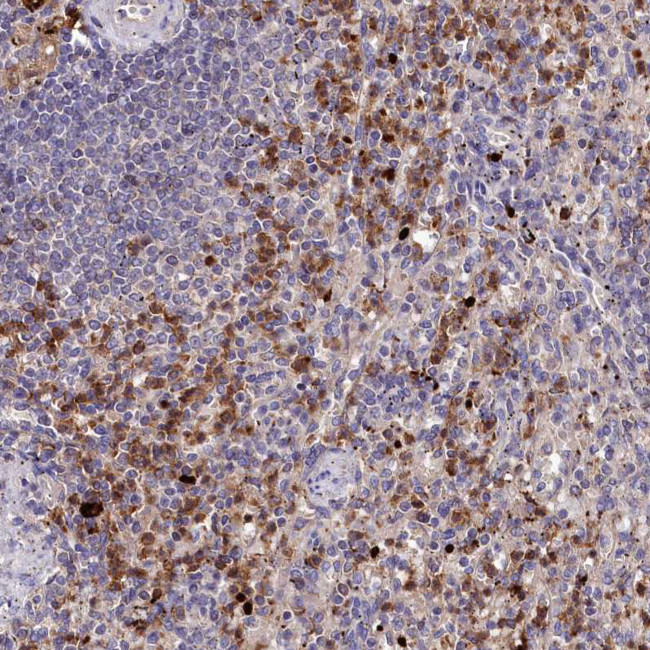
KLRB1 Antibody in Immunohistochemistry (Paraffin) (IHC (P))

Search
Invitrogen
KLRB1 Polyclonal Antibody
{{$productOrderCtrl.translations['antibody.pdp.commerceCard.promotion.promotions']}}
{{$productOrderCtrl.translations['antibody.pdp.commerceCard.promotion.viewpromo']}}
{{$productOrderCtrl.translations['antibody.pdp.commerceCard.promotion.promocode']}}: {{promo.promoCode}} {{promo.promoTitle}} {{promo.promoDescription}}. {{$productOrderCtrl.translations['antibody.pdp.commerceCard.promotion.learnmore']}}
产品信息
PA5-83449
种属反应
宿主/亚型
分类
类型
抗原
偶联物
形式
浓度
规格
纯化类型
保存液
内含物
保存条件
运输条件
RRID
产品详细信息
Immunogen sequence: KCSVDIQQSR NKTTERPGLL NCPIYWQQLR EKCLLFSHTV NPWNNSLADC STKESSLLLI RDKDELIH
Highest antigen sequence indentity to the following orthologs: Mouse - 44%, Rat - 44%.
靶标信息
KLRB1 (Killer cell lectin like receptor subfamily B, member 1, CD-161) protein is classified as a type II membrane protein because it has an external C terminus. KLRB1 cell surface antigen is expressed by almost all NK cells and in a small subset of CD3+ve T cells. KLRB1 is a homodimeric cell surface protein, comprising two chains with molecular weights ranging from 40-44kDa. KLRB1 plays an inhibitory role on natural killer (NK) cells. Activation of KLRB1 leads to acid sphingomyelnase/SMPD1 stimulation and an increase in intracellular ceramide. Moreover, there is also an activation of AKT1/PKB and RPS6KA1/RSK1 kinase stimulation, and T cell proliferation by anti-CD3. KLRB1 acts as a lectin that binds to the terminal carbohydrate Gal-alpha(1,3)Gal epitope and to the N-acetyllactosamine epitope. KLRB1 also binds to CLEC2D/LLT1 as a ligand, and inhibits NK cell-mediated cytotoxicity as well as interferon-gamma secretion in target cells. The KLRB1 protein contains an extracellular domain with several motifs characteristic of C-type lectins, a transmembrane domain, and a cytoplasmic domain.
仅用于科研。不用于诊断过程。未经明确授权不得转售。
篇参考文献 (0)
生物信息学
蛋白别名: C-type lectin domain family 5 member B; CD161; HNKR-P1a; Killer cell lectin-like receptor subfamily B member 1; killer cell lectin-like receptor subfamily B, member 1; MGC138614; natural killer cell receptor; Natural killer cell surface protein P1A; NKR-P1A; unnamed protein product
基因别名: CD161; CLEC5B; hNKR-P1A; KLRB1; NKR; NKR-P1; NKR-P1A; NKRP1A
UniProt ID: (Human) Q12918
Entrez Gene ID: (Human) 3820